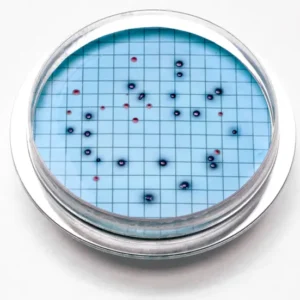

Meter BD Shop
 Gas Detectors Equipment245 products
Gas Detectors Equipment245 products
 Online Equipment1,183 products
Online Equipment1,183 products
 Water Testing Equipment1,606 products
Water Testing Equipment1,606 products
 Soil Testing Equipment323 products
Soil Testing Equipment323 products
 Lab Testing Equipment4,572 products
Lab Testing Equipment4,572 products
 Livestock Equipment252 products
Livestock Equipment252 products
 Seed Testing Equipment29 products
Seed Testing Equipment29 products
 Environment Monitoring506 products
Environment Monitoring506 products
 Medical Equipment1,507 products
Medical Equipment1,507 products
 Moisture Meter153 products
Moisture Meter153 products
Showing 6701–6750 of 10371 resultsSorted by latest